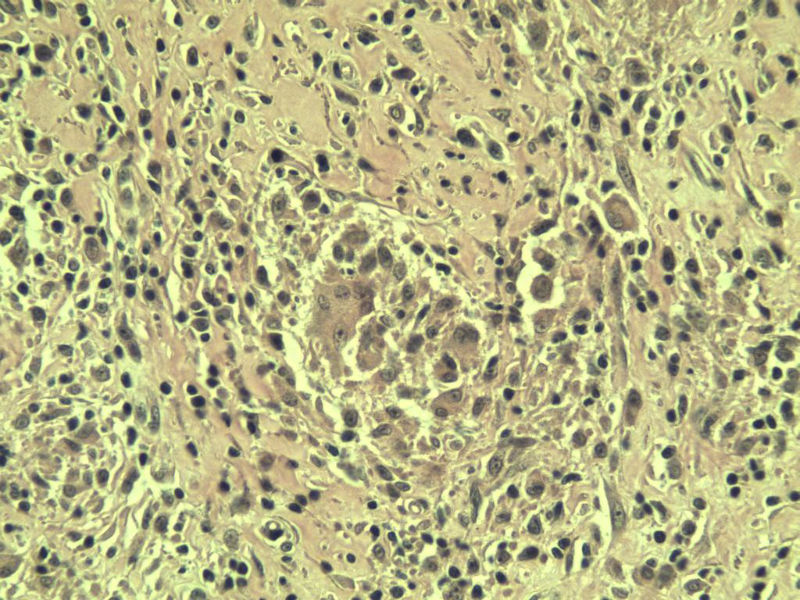
乳腺包块图8
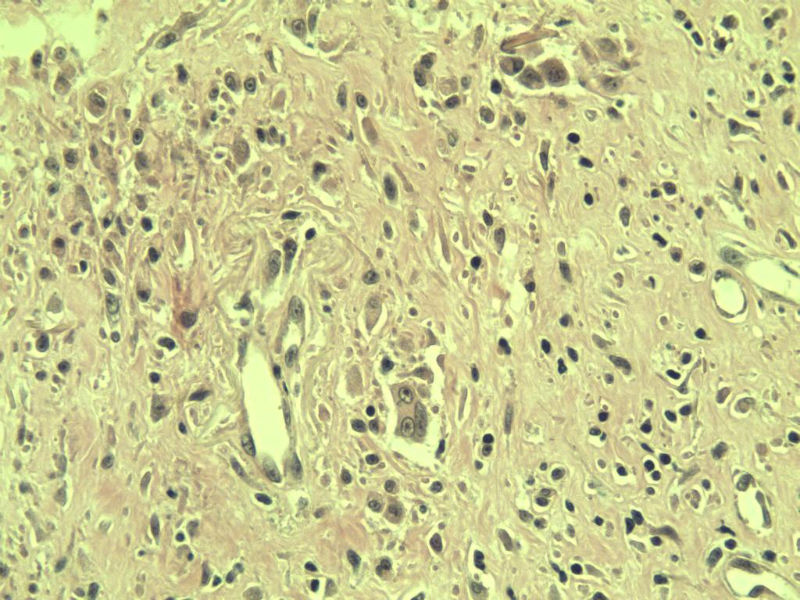
乳腺包块图11

| 图片: | |
|---|---|
| 名称: | |
| 描述: | |
- B3852乳腺包块

名称:图1
描述:a403.Jpg

名称:图2
描述:a404.Jpg

名称:图3
描述:a405.Jpg

名称:图4
描述:a406.Jpg

名称:图5
描述:a407.Jpg

名称:图6
描述:a408.Jpg

名称:图7
描述:a409.Jpg
名称:图8
描述:a410.Jpg

名称:图9
描述:a411.Jpg

名称:图10
描述:a412.Jpg
名称:图11
描述:a413.Jpg

名称:图12
描述:a414.Jpg

名称:图13
描述:a415.Jpg

名称:图14
描述:a416.Jpg
标签:乳腺肉芽肿性炎 乳腺炎症
相关帖子
- • 乳腺结核?
×参考诊断
















